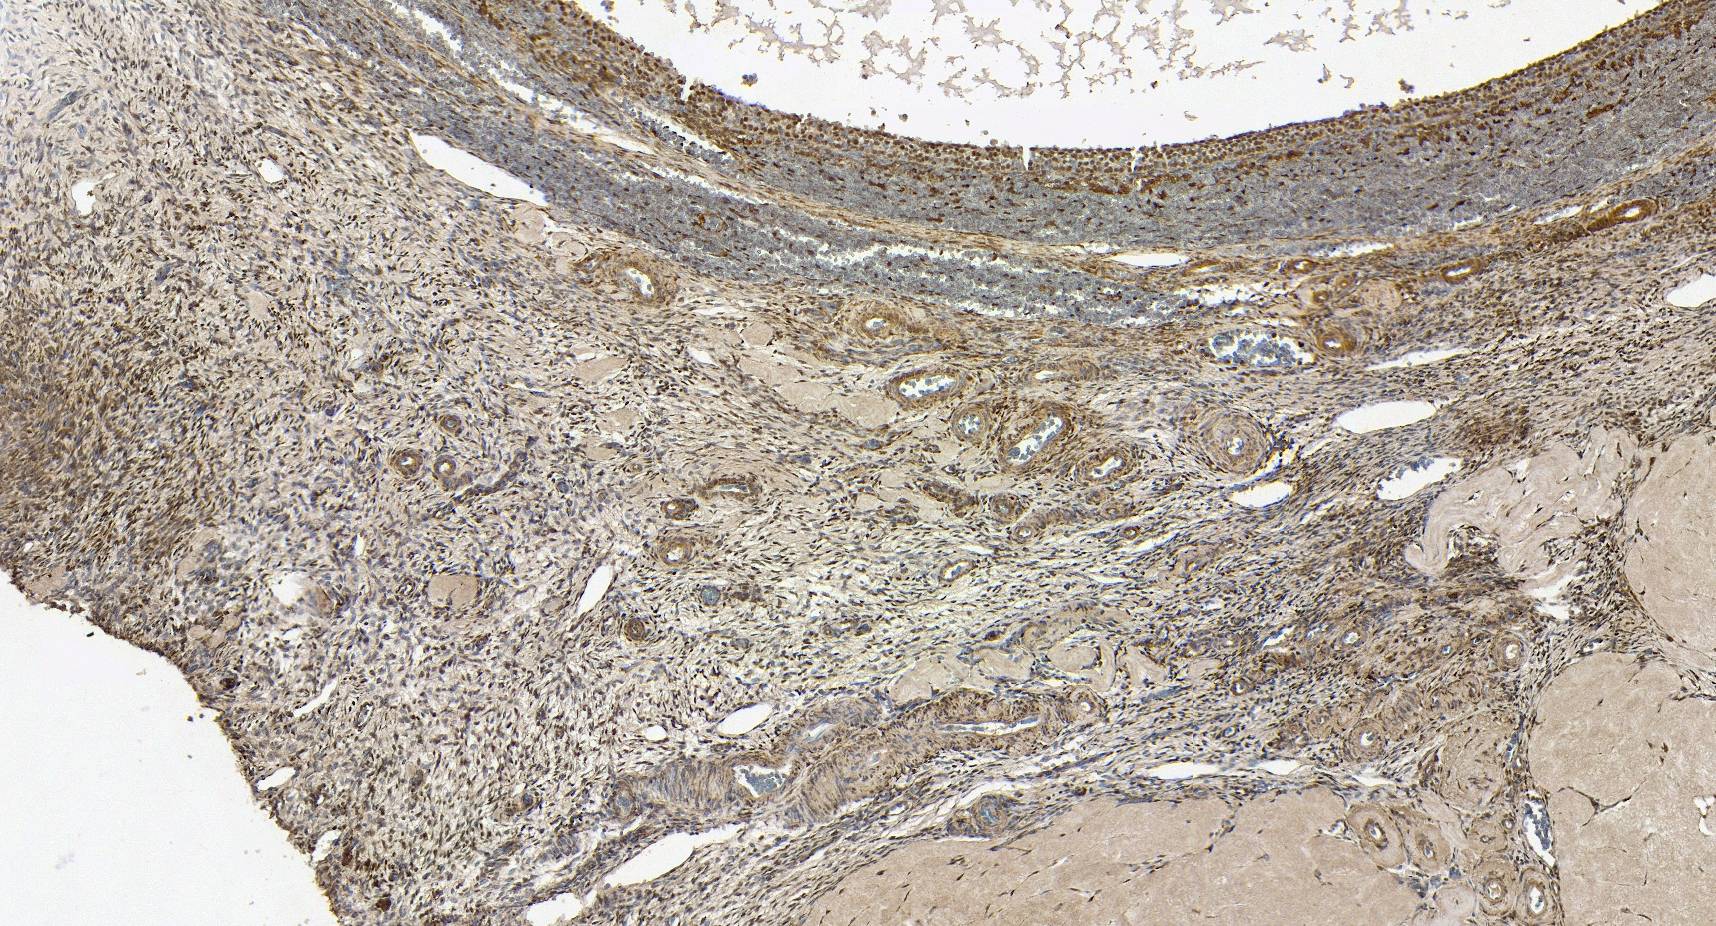

Anti-FOXL2 Antibody - Identical to Abcam (ab5096), Novus (NB100-1277), Sigma (SAB2500415), and Thermo (PA5-18175)
A83945
ApplicationsWestern Blot, ELISA, ImmunoHistoChemistry
Product group Antibodies
ReactivityHuman, Mouse
Overview
- SupplierAntibodies.com
- Product NameAnti-FOXL2 Antibody - Identical to Abcam (ab5096), Novus (NB100-1277), Sigma (SAB2500415), and Thermo (PA5-18175)
- Delivery Days Customer7
- ApplicationsWestern Blot, ELISA, ImmunoHistoChemistry
- CertificationResearch Use Only
- ClonalityPolyclonal
- Concentration500 ug/ml
- ConjugateUnconjugated
- HostGoat
- IsotypeIgG
- Scientific DescriptionGoat polyclonal antibody to FOXL2.
- ReactivityHuman, Mouse
- UNSPSC12352203